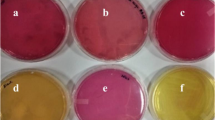

Abstract
Since the construction industry is raising at 0.8–1.2%/yr the concrete utilization growth is assumed to 3.7–4.4 billion tonnes by 2050. Cement is the major composite of concrete. However, its manufacturing contributes approximately 10% of global CO2 emissions and other greenhouse gases. Worldwide, production of cement for concrete makes it 3rd ranking producer of anthropogenic CO2 followed by transport and energy generation. Despite the importance of cement-concrete for construction, it causes several adverse impacts on environment as well as human health at all stages of its manufacturing. In view of these adverse impacts a new term “Bioconcrete” has been originated. It is the self-healing form of concrete in which an ecofriendly key ingredient i.e. Biocement is added. This healing agent can stay dormant for many years and can become active only in the presence of water. Therefore, in modern civilization, MICP derived Biocement-bioconcrete can be the suitable alternative for eco-friendly construction. This chapter presents the overview of Bio Concrete. It describes the need for Biocement and Bioconcrete and the significant mechanism of Biomineralization/Bioprecipitation. The chapter represents the detailed method of MICP, i.e., Microbially induced calcium carbonate precipitation including all the possible pathways. It emphasizes triggering the metabolic pathways by various microbes for synthesis of Biocement-Bioconcrete. The chapter also discusses various factors influencing performance of MICP. Besides, it illustrates the current limitation for commercialization of such self-healing construction material along with numerous potential applications. Furthermore, it highlights the future perspectives of these materials in the upcoming era as a promising and self-healing ecofriendly material of choice for green construction.
Access provided by Autonomous University of Puebla. Download chapter PDF
Similar content being viewed by others
Keywords
29.1 Cement-Concrete
Concrete is a highly demanded versatile material of the construction industry. It has been used extensively as qualities like availability, durability, high compressive strength, compatibility with reinforcement bars, and simple preparation are associated with it. It is chosen easily for various applications due to its low cost and can be casted in different shapes and sizes of desire. By the year 2050, worldwide consumption of concrete is expected to rise to 3.7–4.4 billion tones as the growth of the construction industry is rising yearly at 0.8–1.2% (Benhelal et al. 2013).
In spite of its huge importance in construction, concrete affects the environment and human health at all stages of its manufacturing process (Ivanov et al. 2015) which contributes to emission of carbon-di-oxide (approximately 10% of global emission) (Fig. 29.1). Worldwide, production of cement for concrete makes it 3rd ranking producer of anthropogenic CO2 followed by transport and energy generation. This reflects the exclusive and universal significance of concrete in worldwide construction industry. Therefore, considering the adverse environmental impact of concrete production, various features like extraction of materials causing habitat damage and huge energy consumption, production and transportation may be emphasized.
Concrete manufacturing and its impact on environment (adapted and redrawn after: https://www.greenspec.co.uk)
Cement is the major composite of concrete, which is normally used for binding the aggregates and filling the pore spaces in between fine and coarse particles. The principal hydraulic cement–Portland, has very great demand but being very energy-intensive materials of concrete, this cement is producing greenhouse gases. It is reported that, four GJ (Gigajoule) energy is required to producing 1 tonne of portland cement and manufacturing of portland cement clinker produces approximately one ton of CO2 into the atmosphere (Malhotra 1999; Mehta 1999).
The top-soil is destroyed and lost due to extensive deforestation as a result of mining raw materials like limestone, clay and fuel including coal. Ninety two percent of the energy is used to produce concrete containing only 9–13% cement causing adverse impact on the health of workers as well on the environment (Kubba 2012).
Besides impact on the environment, concrete forms cracks to allow penetration of aggressive chemicals in the structure. The cracks are an indication of concrete deterioration reducing its durability. At an early age, cracks do not threaten its strength. But for a long time, the concrete lifespan may face serious risk (Jonkers 2011). Worldwide, considerable budget is wasted annually to repair the existing cementitious structures (Cailleux and Pollet 2009). It is stated that $147 per m3 of concrete involves the direct cost of maintenance of cracks repair, although production of concrete costs $65–$80 per m3 (Silva 2015). Therefore, preventive measures are very crucial to hinder and finish formation of crack at an early stage.
Research on adverse impacts of building materials on users’ health was started in 1970. In this context, gypsum binders, paints and wood based materials along with blocks of silica etc. were introduced for promotion of human health and protection of the environment. Therefore a need to produce and design various green construction materials supporting to decrease pollution (Stanaszek-Tomal 2020; Häkkinen and Belloni 2011; Chen et al. 2019).
In view of environmental and health impact on society by the process of concrete manufacturing, new term “Bioconcrete'’ has been originated. It is the self-healing form of concrete in which an eco friendly key ingredient i.e. Biocement is added which shows self–healing potential. This healing agent can stay dormant for many years and can become active only in the presence of water. Therefore to overcome the adverse environmental and health impact, Biocement based bio concrete can be the suitable alternative for green construction (Mortensen et al. 2011).
29.2 Biocement
Biocement is the mixture of different component which can alter the pH as well as start binder precipitation, enzymes, live cells of microbes, dead but enzymatically active biomass of microbes catalyzing the changes in pH and or other biochemical reactions as well inorganic constituents makes the binding material.
Presently, it is being explored as a bio-based green material in diverse fields for wide applications. Bio concrete is prepared by adding or bacteria exhibiting the ability of CaCO3 precipitation with the mechanism of Microbial Induced Carbonate Precipitation (MICP). Biocement is an integral part of bioconcrete, produced via MICP mechanism and Calcium carbonate is the appropriate grout for Bio Concrete due to significant compatibility with the cementitious alignments. Due to the property of self-healing along with the up gradation of durability and mechanical features of concrete constructions, it has gained extensive attention from the last few decades. Moreover, coming up as eco friendly–economic technology due to its the repair–maintenance cost and less emissions of carbon dioxide (Castro-Alonso et al. 2019). Although, there are around fifteen different kinds of Biocement, microbial induced calcite precipitation induced Biocement is very popular (Volodymyr and Viktor 2019).
29.3 Biomineralization/Bioprecipitation
Biomineralization/bioprecipitation takes place due to chemical variation in the environment by various microbial activities, resulting in precipitation of minerals (Periasamy et al. 2016). Biomineralization process is well-known and mediated by various microorganisms like algae, fungi, bacteria, protists, and plants etc. Basically, these Bio minerals can be found everywhere, in the form of shells, bone, and teeth, coral reefs, limestone caves offering the amazing solutions for various environmental and engineering issues (Mostafa and Aydin 2019).
Schematic representation of bacterial structure and production of CaCO3 is shown in Fig. 29.2.
Diagrammatic representation of structure of bacteria and synthesis of CaCO3 a structure of bacteria, b cell wall of bacteria with negative and positive charged ions, c bio minerals synthesis by ions binding to bacterial cell walls (adapted and redrawn after: Mostafa et al. 2016)
Generally, Biomineralization/Bio precipitation of minerals in bacteria occurs via following three mechanisms.
29.3.1 BCM (Biologically Controlled Mineralization)
BCM could be intra-cellular i.e. BCMin, extracellular i.e. BCMe and intercellular i.e. BCMint with participation of exopolysaccharides or vesicles (Weiner and Dove 2003; Castro-Alonso et al. 2019).
29.3.2 BIM (Biologically Induced Mineralization)
In BIM, the minerals are indirectly mineralized because of interactions of the metabolic byproduct and the ions associated with their surroundings. These minerals are identified by variations in the size of particulate matter, morphology and reduces the crystallinity (Weiner and Dove 2003; Castro-Alonso et al. 2019).
29.3.3 BMM (Biologically Mediated Mineralization)
In BMM, the mineralization process occurs due to interaction of organic and or inorganic matrices without any intracellular or extracellular bioactivity (Weiner and Dove 2003; Castro-Alonso et al. 2019). However, among the large mineral production via bio-mineralization, precipitation of CaCO3 is of interest to the scientific community because of its excellent bonding capability as well as compatibility with concrete compositions.
29.4 MICP (Microbially Induced Calcium Carbonate Precipitation)
This mechanism attracted the scientific community due to its potential for diverse applicability. Usually, Calcium carbonate crystals are formed by metabolites reaction synthesized by CO32−, enriched in Ca2+environment. Four essential factors viz. DIC i.e. dissolved inorganic carbon, presence of sites of nucleation, concentration of Ca2+ as well as the pH of medium have been reported as the essential factors affecting the precipitation of CaCO3 (Hammes and Verstraete 2002). Carbonate is also reported in tidal flats, coral reefs, fluviatile tufas, lacustrine whitings, cavecrusts, and hot-spring travertines. Besides, in the sub aerial calcrete, few other coatings, grains, matrices etc. inside the sediments (Riding 2000).
Microbes like heterotrophs and autotrophs show ability for precipitation of CaCO3 by various pathways like urea hydrolysis, reduction of iron, sulphate, denitrification, Photosynthesis, ammonification, Methane oxidation, and anaerobic sulfide oxidation, etc. The urea hydrolysis is reported to be a dominating process during the photosynthesis of terrestrial systems. It is also reported that sulphate reduction is dominant in aquatic habitats (Rusznyak et al. 2012; Zhu and Dittrich 2016). The MICP reactions include the following.
29.4.1 Ureolysis
Hydrolysis of urea in presence of ureases results in production of CO2 and ammonia, resulting in an increase in pH. The urease enzyme shows Nickel ions at its active site (Krajewska 2009). Ureases are reported to promote. Formation and precipitation of CaCO3 in natural waters, geological sediments and soil etc. (Mobley and Hausinger 1989). The urease enzyme is produced independently without the substrate i.e. induced or constitutive (Mobley et al. 1991). In the MICP, bacterial cells can affect the kind of minerals formed (Douglas and Beveridge 1998; Rodriguez et al. 2012). The Bacillus group is reported for higher synthesis and activity of urease (Achal et al. 2015).
29.4.1.1 Mechanism of Urease Synthesis (Mobley and Hausinger 1989)
In the microbial systems, Urease synthesis can be carried out through different modes as in the constitutive mode, the enzyme activity is expressed per cell and it does not depend on any external factor. Whereas, in the inducible mode, the level of enzyme activity is generally expressed per cell and triggered by the existence of inducer molecules such as urea. In case of the Repressible mode, synthesis is depressed under nitrogen limiting conditions when there is occurrence of ammonia or its precursors. In the Growth Pattern—swarming versus non-swarming growth pattern expresses variation in urease synthesis (Falkinham and Hoffman 1984).
29.4.1.2 MICP by Production of Urease Enzymes
Bacteria synthesize urease enzymes and catalyze urea into NH4 which results in production of carbonate as well as raises the pH at the cell attachment surface. The carbonate precipitation occurs at seven stages. Following reaction shows spontaneous hydrolysis resulting in carbonic acid formation at the surface of the cell (Hammes et al. 2003; Li et al. 2000; Stocks-Fischer et al. 1999; Ferris et al. 1996; Qian et al. 2010).
Figure 29.3 shows bacterial urease activity precipitation of CaCO3 and generation of ATP as: (1) On basis of concentration gradient, urea diffuses into the bacterial cell, (2) urea hydrolysis results into increased because of ammonia production, (3) this ammonia get diffused out of cell as per the concentration gradient and increases cell membrane potential both outside-inside, (4) due to this the proton driving force allows generation of adenosine triphosphate i.e. ATP (Whiffin 2004).
Urease activity with calcium carbonate (adapted and redrawn after: Sandra et al. 2018)
29.4.2 Metabolic Transformation of Organic Compound-Heterotrophic Bacteria
In heterotrophic bacteria aerobic oxidation under alkaline conditions results in increase in pH and carbonate production;
(I) Substrate Lactate
(II) Substrate Acetate
29.4.3 Dissimilatory Nitrate Reduction
Bacterial denitrification leads to increase in pH initiating the MICP without buffering action (Hamdan et al. 2011).
Synthesis of carbonate ion occurs at increased pH and carbon (IV) oxide gas. The reactions are as follow:
29.4.4 Dissimilatory Sulphate Reduction
Under the aerobic conditions, unstable sulphides are biologically oxidized to sulphate which are harmful to concrete (Alexendar and Karen 2012). The reactions are as follow:
29.4.5 Photosynthesis (Castro-Alanso et al. 2019)
The photosynthetic microalgae and cyanobacteria in aquatic environment lead to CaCO3 precipitation (Table 29.1). The reactions are as follow:
The ureolysis pathway for MICP indicating, urea hydrolyzation by the microorganisms in nature (Mobley and Hausinger 1989). This process of hydrolysis is well known for biocement-bio concrete production by bacteria. It is time and cost effective (Dhami et al. 2012).
29.5 Factors Influencing Performance of MICP
29.5.1 Energy Substrates
Nutrients like carbon dioxide, nitrogen, phosphorus, potassium, magnesium, calcium and iron etc. should be provided to microbes during stage of culture and treatment stage so that cell can sustain long enough to support CaCO3 precipitation (Wei-Soon et al. 2012).
29.5.2 Urease Positive Bacteria
Aerobic bacteria are most preferable for urea hydrolysis because it releases CO2 from respiration of the cell, which results in increased pH due to ammonium production. The Urease positive bacteria of genera Sporosarcina spp., Bacillus spp., Sporolactobacillus spp., Clostridium spp., and Desulfotomaculum spp. etc. are used. Usually, the common types of Bacillus spp. are used as, B. sphaericus, B. megaterium and B. pasteurii. Among all types of microorganisms used, Bacillus species is a widely accepted bacterial species utilized for CaCO3 precipitation. However, the variations in calcite synthesis during MICP are observed in Bacillus spp. (Wei-Soon et al. 2012).
29.5.3 Geometric Compatibility of Bacteria
Basically, an appropriate type of bacteria having geometric compatibility is needed for MICP treatment (Wei-Soon et al. 2012). Small pore size is observed to limit free passage of bacteria. This depends on the size of cell and material used (Maier et al. 2009).
29.5.4 Bacterial Cell Concentration
It is reported that higher bacterial concentration increases the synthesis of urease per unit volume (Wei-Soon et al. 2012).
29.5.5 Fixation and Distribution of Bacteria
It is reported that increased salinity in solution encourages flocculation which accelerates the bacterial adsorption as well as withholding capacity in the sand column (Ritvo et al. 2003; Torkzaban et al. 2008). Decreased strength of ions and less strength of adsorption of bacteria in less salinity solution allows transportation over great distances (Harkes et al. 2010). During the fluid fixation, greater flow rate can flush the bacterial cells to comparatively longer distance.
29.5.6 Temperature
Urea hydrolysis is found to occur at higher temperature 30 °C. Increases in temperature do not accelerate decomposition (Nemati et al. 2005). Therefore, it is recommended to exploit bacteria surviving at optimum temperature i.e. approximately 60 °C (Sahrawat 1984).
29.5.7 Reactant Concentration
It is reported that the activity of microbes may be retarded at high salinity thereby, decreases urease synthesis by ureolytic bacteria. Likewise, higher urea and CaCl2 concentration increase the rate of urea decomposition (Rivadeneyra et al. 2004; Nemati et al. 2005; Rivadeneyra et al. 1998).
29.5.8 pH
The optimum pH of urease enzyme is 7.5–8.0 (Stocks-Fischer et al. 1999). It is reported that the activity has decreased above pH 8.0. In the MICP process, pH increases gradually due to release of ammonia, whereas, carbon dioxide released acts as a buffer to control the pH (Wei-Soon et al. 2012).
29.6 Limitations for MICP Derived Biocement-Bioconcrete
Commercial Applications of Biocement-Bio Concrete has few limitations due to following reasons as:
-
Product and performance of MICP has found to vary relating to geographic and environmental condition and needs adaptation.
-
Application of MICP derived Biocement-Bioconcrete at commercial scale is influenced by different environmental factors.
-
Exploitation of potent microbial strain under controlled condition may serve industries to overcome the problem of various hazards and pollution.
-
Till date, the designs of any bioconcrete are not included in is or any other codes.
-
The field conditions and lab situation do not go hand in hand to monitor the production process.
-
Since the construction engineers are less familiar with the microbiological processes, its acceptance is found to affect its commercialization.
-
Standard protocols are not properly developed regarding the testing and acceptance criteria.
29.7 Potential Applications of Biocement/Bio Concrete
-
The MICP can be utilized to increase the extraction efficiency of the crude oil and used to decrease its leakage as well the top soil contamination which is enriched with various microorganisms. Besides, it can be used as a promising solution for strengthening the soil and consolidation of sand (Mostafa and Aydin 2019).
-
The leakages from reservoirs or ponds cause loss of fluid resulting in leakage into the underneath soil or sand. However, this problem can be solved by decreasing the rate of the seepage rate and the permeation of the reservoir via MICP technology (Mostafa and Aydin 2019).
-
It can be helpful in removal of calcium, sequestration of radionuclides, heavy metals and Carbon dioxide. It can also be used for removal of inorganic contaminants (Sandra et al. 2018; Zaghloul et al. 2020; Periasamy et al. 2016).
-
In the material engineering, ecofriendly technologies are needed to produce materials–composite showing less resource exhaustion and energy consumption. Thereby MICP can be used as an alternative (Periasamy et al. 2016).
-
It can be efficiently used for prevention of concrete corrosion and cracks (Zaghloul et al. 2020).
-
MICP based biocement shows noteworthy improvement w.r.t. the robustness of constructions and can decrease the amount of cement used in it without compromising its quality in a cost-effective manner (Achal et al. 2014; Sandra et al. 2018).
-
MICP process could help to understand numerous natural biological phenomena and applications in geo-microbiological processes viz.: treatment of Ca-rich wastewater, leaching minimization from channels and reservoirs, purification of groundwater, repairing of constructions and in situ improvement of the mechanical properties of soil (Jian et al. 2012).
-
MICP derived Biocement-Bioconcrete shows remarkable eco-friendly ability. Also, the Biocementation can achieve better mechanical strengths in comparison to conventional cement (Veerappan and Chandru 2016).
-
Moreover, it can be used for manufacturing mould and other biocemented products. It can be applicable in the earth stabilisation for mining, tunneling, and earthquake repair, repairing or deteriorating “masonry and built structures”, “instant pavement”, “filters, ornamental and structural blocks” etc. (Veerappan and Chandru 2016).
-
It increases the compressive strength of concrete and mortar up around 38%. It could make the process economical, by using various industrial by products. Utilization of microbial additives can also increase the long-life of the bio concrete structures. In this way, it can be more efficiently used as compared to an ordinary cement-concrete (Laxmana et al. 2015)
-
Various cultural heritage objects are impaireddue to micro cracks causing expenses. In this case, the CaCO3 precipitation derived from bacteria can be proved as the best substitute for micro–crack repairing technique in an environmentally friendly manner (Annamalai et al. 2013).
29.8 Future Perspectives
-
The use of urease and carbonic anhydrase enzymes in MICP processes needs to be metabolically controlled.
-
The research and development study to formulate hardening of concrete is the need of the hour.
-
Extensive research is needed for bond coherence to avoid crack formation.
-
It is necessary to genetically engineered bacterial strains which would have long sustainability during ureolysis.
-
Successful commercialization of MICP biconcrete process could be designed with alteration in the energy substrates and physiological conditions.
-
If the reliable and reproducible research related to MICP derived biocement-bioconcrete production process will successfully achieved and documented, this ecofriendly technology can be efficiently used for large scale commercialization.
Therefore, in the upcoming era, the bioconcrete can come up as a promising and self-healing eco-friendly material of choice for green construction.
29.9 Conclusion
Worldwide, production of cement for concrete makes it 3rd ranking producer of anthropogenic CO2 followed by transport and energy generation. Bioconcrete is the self-healing form of concrete in which an ecofriendly key ingredient i.e. Biocement is added. This healing agent can stay dormant for many years and can become active only in the presence of water. It is expected that for large production of ecofriendly bioconcrete, development of new competitive bacterial strains is needed. This is because the synthetic cement has several unwanted impacts on Environment as well as human health. In view of this, microbiological and molecular research may overcome the hazardous effect by production of cost-effective Bioconcrete. Therefore, the extensive research related to MICP derived products is the need of the upcoming era. The Bioconcrete could be a promising and self-healing ecofriendly material of choice for green construction.
References
Achal V, Li M, Zhang Q (2014) Biocement, recent research in construction engineering: status of China against the rest of the world. Adv Cem Res 26(5):281–291. https://doi.org/10.1680/adcr.13.00044
Achal V, Mukherjee A, Kumari D, Zhang Q (2015) Biomineralization for sustainable construction—a review of processes and applications. J Mater Civil Eng Earth Sci Rev 23(6):730–734. https://doi.org/10.1016/j.earscirev.2015.05.008
Alexander Q, Karen LS (2012) Hydration of C3A-gypsum systems. Laboratory Construction Materials Station 12, CH-1015, Lausanne, pp 52–56
Annamalai SK, Arunachalam KD, Sathyanarayanan S, Prasanth Kumar VR (2013) Asian J Chem 25:143–146
Benhelal E, Zahedi G, Shamsaei E, Bahadori A (2013) Global strategies and potentials to curb CO2 emissions in the cement industry. J Clean Prod 51:142–161
Cailleux E, Pollet V (2009) Investigations on the development of self-healing properties in protective coatings for concrete and repair mortars. Paper presented at the 2nd international conference on Self-Healing Materials, Chicago, IL, USA
Castro-Alonso MJ, Montañez-Hernandez LE, Sanchez-Muñoz MA, Macias Franco MR, Narayanasamy R, Balagurusamy N (2019) Microbially induced calcium carbonate precipitation (MICP) and its potential in bioconcrete: microbiological and molecular concepts. Front Mater 6:126. https://doi.org/10.3389/fmats.2019.00126
Chen ZS, Martinez L, Chang JP, Wang XJ, Xiong SHI, Chin KS (2019) Sustainable building material selection-A QFD- and ELECTRE III-embedded hybrid MCDM approach with consensus building. Eng Appl Artif Intell 85:783–807
Dhami NK, Redy MS, Mukherjee A (2012) Improvement in strength properties of ash bricks by bacterial calcite. Ecol Eng 39:31–35
Douglas S, Beveridge TJ (1998) Mineral formation by bacteria in natural microbial communities. FEMS Microbiol Ecol 26(2):79–88. https://doi.org/10.1016/S0168-6496(98)00027-0
Falkinham JO, Hoffman PS (1984) Unique developmental characteristics of the swarm and short cells of Proteus vulgaris and Proteus mirabilis. J Bacteriol 158:1037–1040
Ferris FG, Stehmeier LG, Kantzas A, Mourits FM (1996) Bacteriogenic mineral plugging. J Can Petrol Technol 35:56–61
HäkkinenT BK (2011) Barriers and drivers for sustainable building. Build Res Inform 39:239–255
Hamdan N, Kavazanjian E, Rittman BE (2011) Carbonate mineral precipitation for soil improvement through microbial denitrification. Adv Geochem Eng Dallas American Society of Civil Engineers 21–23
Hammes F, Verstraete W (2002) Key roles of pH and calcium metabolism in microbial carbonate precipitation. Rev Environ Sci Biotechnol 1(1):3–7
Hammes F, Boon N, Clement G, Villiers JD, Siciliano SD, Verstraete W (2003) Molecular, biochemical and ecological characterisation of a bio-catalytic calcification reactor. Appl Microbiol Biotechnol 62:191–201
Harkes MP, Van Paassen LA, Booster JL (2010) Fixation and distribution of bacterial activity in sand to induce carbonate precipitation for ground reinforcement. Ecol Eng 36:112–117
Ivanov, Chu J, Stadnikov V (2015) Basics of construction microbial biotechnology in biotechnologies and biomimetics for civil engineering. Springer, Berlin, Germany, pp 21–56
Jian C, Viktor S, Volodymyr I (2012) Microbially induced calcium carbonate precipitation on surface or in the bulk of soil. Geomicrobiol J 29(6):544–549
Jonkers HM (2011) Bacteria-based self-healing concrete. Heron 56(1–2):5–16
Krajewska, (2009) Ureases functional catalytic and kinetic properties. J Mol Catal B-Enzym. https://doi.org/10.1016/j.molcatb.2009.01.003
Kubba S (2012) Handbook of green building design and construction: LEED, BREEAM, and Green Globes. Butterworth-Heinemann Ed, Oxford
Laxmana RR, Manjusha A, Arunkumar M (2015) Bio cement—an ecofriendly construction material. Int J Curr Eng Technol 5(4):2880–2883
Li YH, Chen YYM, Burne RA (2000) Regulation of urease gene expression by Streptococcus salivarius growth in biofilms. Environ Microbiol 2:169–177
Maier RM, Pepper IL, Gerba CP (2009) Environmental Microbiology, 2nd edn. Elsevier Science, China, p 366
Malhotra VM (1999) Making concrete greener with fly ash. Concr Int 21(5):61–66
Mehta PK (1999) Concrete technology for sustainable development. Concr Int 21(11):47–53
Mobley H, Hausinger (1989) Microbial ureases significance regulation and molecular characterisation. Microbiol Rev 53(1):85–108
Mobley HL, Chippendale GR, Swihart KG, Welch RA (1991) Cytotoxicity of the Hpm Ahemolysin and disease of Proteus mirabilis and Proteus vulgaris against cultured human renal proximal tubular epithelial cells. Infect Immun 59(6):2036–2042
Mortensen BM, Haber MJ, De Jong JT, Caslake LF, Nelson DC (2011) Effects of environmental factors on microbial induced calcium carbonate precipitation. J Appl Microbiol 111(2):338–349
Mostafa S, Aydin B (2019) Microbially induced calcium carbonate precipitation a widespread phenomenon in the biological world. Appl Microbiol Biotechnol 103:7
Mostafa S, Ali KS, Aydin B (2016) Bioconcrete next generation of self-healing concrete. Appl Microbiol Biotechnol 100:2591–2602
Nemati M, Greene EA, Voordouw G (2005) Permeability profile modification using bacterially formed calcium carbonate comparison with enzymic option. Process Biochem 40:925–933
Periasamy CHK, Yu JS, Jane S (2016) Formations of calcium carbonate minerals by bacteria and its multiple applications. Springerplus 5:250
Qian G, Wang R, Cheng L, Wang J (2010) Theory of microbial carbonate precipitation and its application in restoration of cement-based materials defects. Chinese J Chem 28(5):847–857. https://doi.org/10.1002/cjoc.201090156
Riding R (2000) Microbial carbonates the geological record of calcified bacterial algal mats and biofilms. Sedimentology 47:179–214
Ritvo G, Dassa O, Kochba M (2003) Salinity and pH effect on the colloidal properties of suspended particles in super intensive aquaculture systems. Aquaculture 218:379–386
Rivadeneyra MA, Delgado G, Ramos CA, Delgado R (1998) Biomineralization of carbonates by halomonas euryhaline in solid and liquid media with different salinities crystal formation sequence. Res Microbiol 149:277–287
Rivadeneyra MA, Párraga J, Delgado R, Ramos CA, Delgado G (2004) Biomineralization of carbonates by Halobacillus trueperi in solid and liquid media with different salinities. FEMS Microbiol Ecol 48:39–46
Rodriguez NC, Ground SM, Ruiz AE, Gonzalez MT (2012) Influence of substrate mineralogy on bacterial mineralization of calcium carbonate implications for stone conservation. Appl Environ Microb 78(11):4017–4029. https://doi.org/10.1128/AEM.07044-11
Rusznyak A, Akob DM, Nietzsche S, Eusterhues K, Totsche KU, Neu TR (2012) Calcite biomineralization by bacterial isolates from the recently discovered pristine karstic herrenberg cave. Appl Environ Microbiol 78:1157–1167
Sahrawat K (1984) Effects of temperature and moisture on urease activity in semi arid tropical soils. Plant Soil 78:401–408
Sandra PCA, Becerra Jiménez ML, Martínez-Zambrano JJ, Rojas Sarmiento HA (2018) Soil bacteria that precipitate calcium carbonate mechanism and applications of the process. Acta Agron 67(2):277–288
Silva FB (2015) Industrial applications of biological self-healing concrete challenges and economical feasibility. J Commer Biotechnol 21(1):31–38
Stanaszek-Tomal E (2020) Bacterial concrete as a sustainable building material. Sustainability 12(2):696
Stocks-Fischer FS, Galinat JK, Bang SS (1999) Microbiological precipitation of CaCO3. Soil Biol Biochem 31:1563–1571
Torkzaban S, Tazehkand SS, Walker SL, Bradford SA (2008) Transport and fate of bacteria in porous media coupled effects of chemical conditions and pore space geometry. Water Resource Res 44:W04403
Veerappan K, Chandru PA (2016) Brief review on biocement based concrete. Int J Eng Manag Res 6(5):142–144
Volodymyr VS (2019) Sustainable and safe construction biomaterials biocements and biogrouts. Front Biomater 6:177–193
Weiner S, Dove PM (2003) An overview of biomineralization processes and the problem of the vital effect. Rev Mineral Geochem 54:1–29. https://doi.org/10.2113/0540001
Wei-Soon NG, Min-Lee L, Siew-Ling H (2012) An overview of the factors affecting microbial-induced calcite precipitation and its potential application in soil improvement. Int Sch Sci Res Innov 6(2):188–194
Whiffin VS (2004) Microbial CaCO3 precipitation for the production of biocement. Doctoral dissertation, Murdoch University
Zaghloul EH, Ibrahim IYAH, ElBadan DES (2020) Production of biocement with marine bacteria Staphylococcus epidermidis EDH to enhance clay water retention capacity. Egypt J Aquat Res. https://doi.org/10.1016/j.ejar.2020.08.005
Zhu T, Dittrich M (2016) Carbonate precipitation through microbial activities in natural environment, and their potential in biotechnology. Front Bioeng Biotechnol 4:4
Acknowledgements
The authors are grateful to the Research and Development Department, Sigma Wineries Pvt. Ltd. Nashik. Special thanks to Mr. V.C. Handore, Mrs. Hira V. Handore, and Ms. V. Jagtap for valuable technical assistance.
Author information
Authors and Affiliations
Editor information
Editors and Affiliations
Rights and permissions
Copyright information
© 2022 The Author(s), under exclusive license to Springer Nature Switzerland AG
About this chapter
Cite this chapter
Handore, A.V., Khandelwal, S.R., Karmakar, R., Jagtap, A.S., Handore, D.V. (2022). Bioconcrete: The Promising Prospect for Green Construction. In: Malik, J.A., Marathe, S. (eds) Ecological and Health Effects of Building Materials. Springer, Cham. https://doi.org/10.1007/978-3-030-76073-1_29
Download citation
DOI: https://doi.org/10.1007/978-3-030-76073-1_29
Published:
Publisher Name: Springer, Cham
Print ISBN: 978-3-030-76072-4
Online ISBN: 978-3-030-76073-1
eBook Packages: EngineeringEngineering (R0)